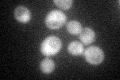
YMR099C
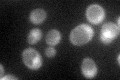
YMR099C

View description
Glucose-6-phosphate 1-epimerase (hexose-6-phosphate mutarotase), likely involved in carbohydrate metabolism; GFP-fusion protein localizes to both the nucleus and cytoplasm and is induced in response to the DNA-damaging agent MMS
Localization:
Intensity:
Fold change:
Significance:
-
C’ GFP library in SD

cytosol47.26 -
N' NOP1pr-GFP in SD

cytosol292.951 -
N' TEF2pr-mCherry in SD

cytosol345.888 -
N' NATIVEpr-GFP in SD

cytosol84.6429 -
N' TEF2pr-VC and Cyto-VN in SD

#N/A0 -
C’ GFP library in SD+DTT

cytosol60.121.27No -
C’ GFP library in SD+H2O2
cytosol55.541.17No -
C’ GFP library in Starvation Media
cytosol70.851.49Yes -
C’ GFP library on the background of Pup2-DaMP

cytosol -
C’ GFP library on the background of CCT mutant

cytosol54.78611.15906No
